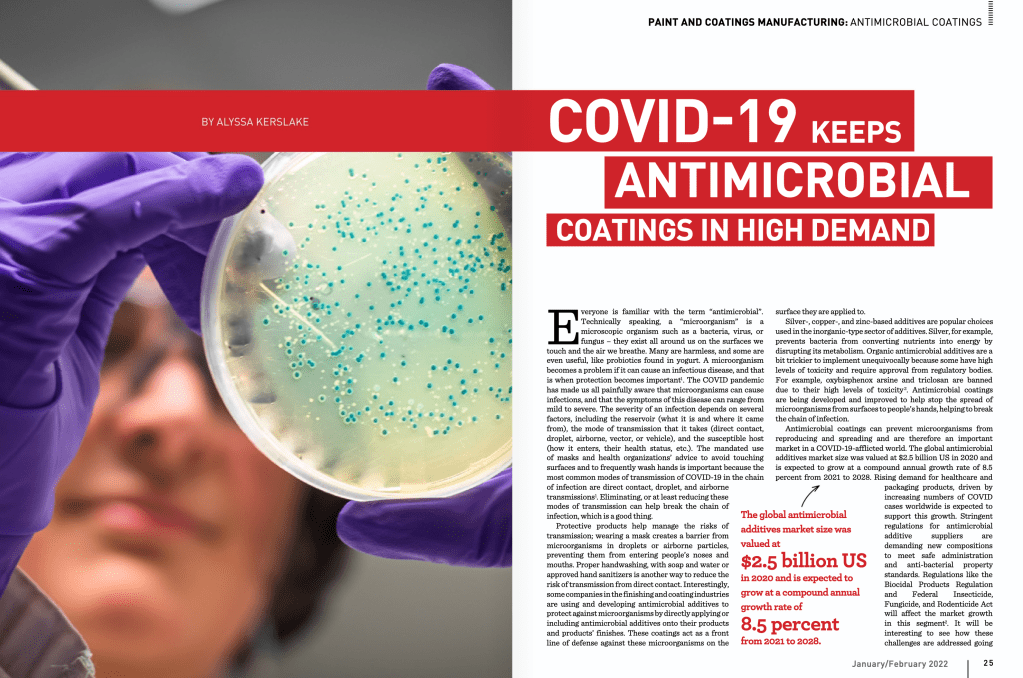

Canadian Finishing & Coatings Manufacturing Magazine – Jan/Feb 2022











Canadian Finishing & Coatings Manufacturing Magazine – March/April 2022


















Canadian Finishing & Coatings Manufacturing Magazine – Jan/Feb 2022

Canadian Finishing & Coatings Manufacturing Magazine – March/April 2022

















